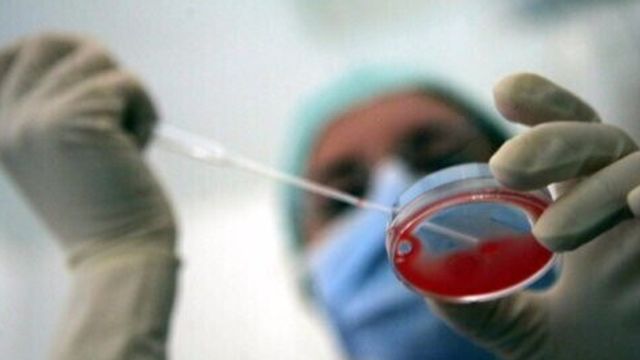

Buone notizie sul fronte della ricerca e della scienza. I progressi nel trattamento dei tumori, hanno portato ad una diminuzione della mortalità nel nostro Paese. L'Italia, fra il 2011 e il 2019, ha registrato una diminuzione della mortalità per cancro superiore rispetto alla media europea, con una riduzione dei decessi del 15% negli uomini e dell'8% nelle donne (-10% uomini e -5% donne in Europa).
L'immunoncologia -
Un obiettivo raggiunto anche grazie all'immunoncologia un nuovo tipo di strategia terapeutica basata sull’impiego dell’immunoterapia come possibile rimedio al cancro. Con un approccio innovativo di cura della malattia, ha cambiato lo standard di cura in diversi tumori, aumentando la sopravvivenza anche nei pazienti in stadio metastatico e con neoplasia contro le quali, fino a soli 10 anni fa, non si disponeva di terapie efficaci, dal melanoma al mesotelioma. L'Italia è in prima linea nella ricerca sull'immunoncologia come afferma Michele Maio, presidente Fondazione Nibit e direttore della Cattedra di Oncologia dell'Università di Siena e del Centro di Immuno-Oncologia dell'Azienda ospedaliero universitaria senese. "Dopo i primi due grandi passi avanti nella sfida ai tumori rappresentati dalla chemioterapia e dalle terapie mirate, negli ultimi dieci anni vi è stata una svolta grazie all'immunoncologia, che oggi è lo standard di cura in diverse neoplasie in stadio metastatico o ad alto rischio di ripresa di malattia dopo la chirurgia: dal melanoma, al tumore del polmone, al mesotelioma, al carcinoma a cellule renali fino a quelli gastrointestinali e genitourinari. E sono in corso studi in molte altre neoplasie".
Melanoma metastatico -
Circa il 50% dei pazienti con melanoma metastatico sviluppa metastasi cerebrali: "con lo studio Nibit-m2, ad esempio, per la prima volta - afferma Maio - abbiamo infranto il dogma per cui l'immunoterapia non funziona in questi casi, e circa il 50% di questi pazienti è vivo e libero da malattia a 5 anni rispetto ai 4-5 mesi a cui eravamo abituati".
Carcinoma polmonare -
Inoltre, oggi "circa il 75% dei casi di carcinoma polmonare, una delle neoplasie più difficili da trattare, è diagnosticato in fase avanzata - spiega Federico Cappuzzo, direttore Oncologia Medica 2, Istituto Nazionale Tumori Regina Elena di Roma -. Anche in questo tumore, l'immunoncologia ha cambiato il paradigma di cura. La duplice immunoterapia, con nivolumab più ipilimumab, in associazione a due cicli di chemioterapia, nel tumore del polmone non a piccole cellule metastatico, a quattro anni ha migliorato la sopravvivenza globale con il 21% dei pazienti vivi rispetto al 16% con la sola chemioterapia".
Il fumo ostacola il trend positivo per le donne -
"Per troppo tempo il tumore del polmone è stato considerato una patologia quasi esclusivamente maschile - spiega Stefania Vallone, Segretario Walce (Women Aganist Lung Cancer in Europe) -. Negli ultimi anni si è registrata una forte crescita anche tra le donne a causa dell'aumento della dipendenza da fumo di sigaretta nella popolazione femminile. La prevenzione primaria è uno dei pilastri della nostra Associazione, che vuole contribuire anche alla diffusione di una maggiore consapevolezza sul significato dell'innovazione terapeutica. Purtroppo, la diagnosi del tumore del polmone è ancora tardiva, ma nuovi strumenti come l'immunoncologia stanno migliorando le possibilità di sopravvivenza a lungo termine, con una buona qualità di vita".
La campagna -
Per raccontare a tutti i cittadini questi importanti risultati, da oggi fino a domenica 18 giugno a Roma si svolge la terza tappa della campagna di sensibilizzazione 'Lo so anch'io', presentata oggi in una conferenza stampa. La campagna prevede incontri nelle piazze, con la presenza delle associazioni dei pazienti e la distribuzione di materiale informativo, e l'attivazione di un portale dedicato (www.bms.com/it/losoanchio.html).